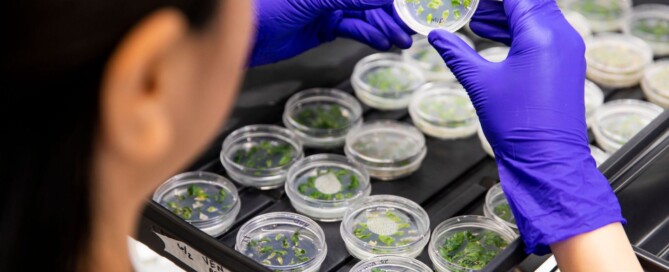

Feds Greenlight ‘Rigorous’ Low-Level Cannabis Prosecutions, Raising Questions Over Whether Biden’s Softer Approach Was Ever Real Policy
A quiet move by the U.S. Department of Justice in late September appears to have reopened the door for federal prosecutors to pursue low-level cannabis cases again. The document itself is not public, but a Justice Department press release from the U.S. Attorney’s Office in Wyoming states that DOJ rescinded earlier guidance on simple marijuana